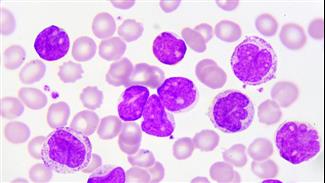
מדוע חלק מהטיפולים החדשים לסרטן הדם אינם נגישים לחולים?

בדיקת מיפוי דרכי לימפה (Lymphoscintigraphy)
בדיקה פיזיולוגית להדגמת דרכי וקישריות הלימפה על ידי הזרקה תת-עורית של חלקיקי קולואיד רדיואקטיבי וצילום התקדמות החומר בדרכי הלימפה.
בין יישומי הבדיקה נכללים: הדגמת הפרעות בניקוז הלימפה בגפיים בשל הפרעה מלידה או נרכשת וכן הדגמת מיקום קישרית הלימפה הראשונה; קשרית הזקיף, המנקזת את הלימפה מאזור סרטן השד ומלנומה.
הקישרית נכרתת ובמידה ואינה נגועה בגרורות, אין צורך בכריתת שאר הקישריות.
ד"ר תפחה הורן
בין יישומי הבדיקה נכללים: הדגמת הפרעות בניקוז הלימפה בגפיים בשל הפרעה מלידה או נרכשת וכן הדגמת מיקום קישרית הלימפה הראשונה; קשרית הזקיף, המנקזת את הלימפה מאזור סרטן השד ומלנומה.
הקישרית נכרתת ובמידה ואינה נגועה בגרורות, אין צורך בכריתת שאר הקישריות.
ד"ר תפחה הורן
רמת סיכון:
אין נתוניםשאלות ותשובות
- אני בת 39. לפני כשנה נמצא אצלי גוש בשד. בוצע ניקור שד ונלקחה ביופסיה שאלה תוצאותיה: מבנה פיברוציסטי צפוף המגביל את הבדיקה, הדגמה של גוש עגול 30 מ"מ עם גבולות חדים. תיאור מאקרוסקופי: התקבלה מבחנה עם נוזל בצבע צהוב עכור בנפח 5 סמ"ק. במש
- אני בת 35, אחרי שתי לידות בעקבות טיפולי פוריות. ההריון הראשון הושג לאחר הזרקות הורמונים והשני לאחר IVF שני. כמה חודשים לאחר הלידה שמתי לב שיש לי דימומים מדי פעם והכתמות בין המחזורים. בחודשיים הראשונים ייחסתי זאת לחזרה לגלולות למניעת הריון, עד שהגוף י
- אודה אם תסבירו לי את תוצאות בדיקת ה- PET של חולה בת 52: קליטה מוגברת של FDG בדופן בית חזה שמאל, בעור השד הימני, וכן לימפאדנופתיה קולטת בצוואר התחתון באזורים הסופרה-קלביקולרים בבתי השחי משני צדדים. קשה להבדיל אם מדובר בלימפאדנופתיה שאתית או תגוב
מאמרים בנושא מיפוי דרכי לימפה

מדוע חלק מהטיפולים החדשים לסרטן הדם אינם נגישים לחולים?
מאת: מערכת אינפומד 14/09/2016
מאת: מערכת אינפומד 14/09/2016מדי שנה מאובחנים אלפי ישראלים כחולים בסרטן הדם, ולמרות שקיים שיא במספר התרופות החדשות לטיפול במחלות סרטן הדם - עדיי... לכתבה המלאה

מחקר: קוקטייל תרופות יאריך חיי חולות סרטן השד
מאת: ברק מידן, מערכת אינפומד 01/10/2014
מאת: ברק מידן, מערכת אינפומד 01/10/2014מחקר חדש מצא ששימוש בתרופה חדשה בשם Perjeta בשילוב עם התרופה הרצפטין, מספק אפקט סינרגיסטי ומאריך לכן את חיי החולות ... לכתבה המלאה